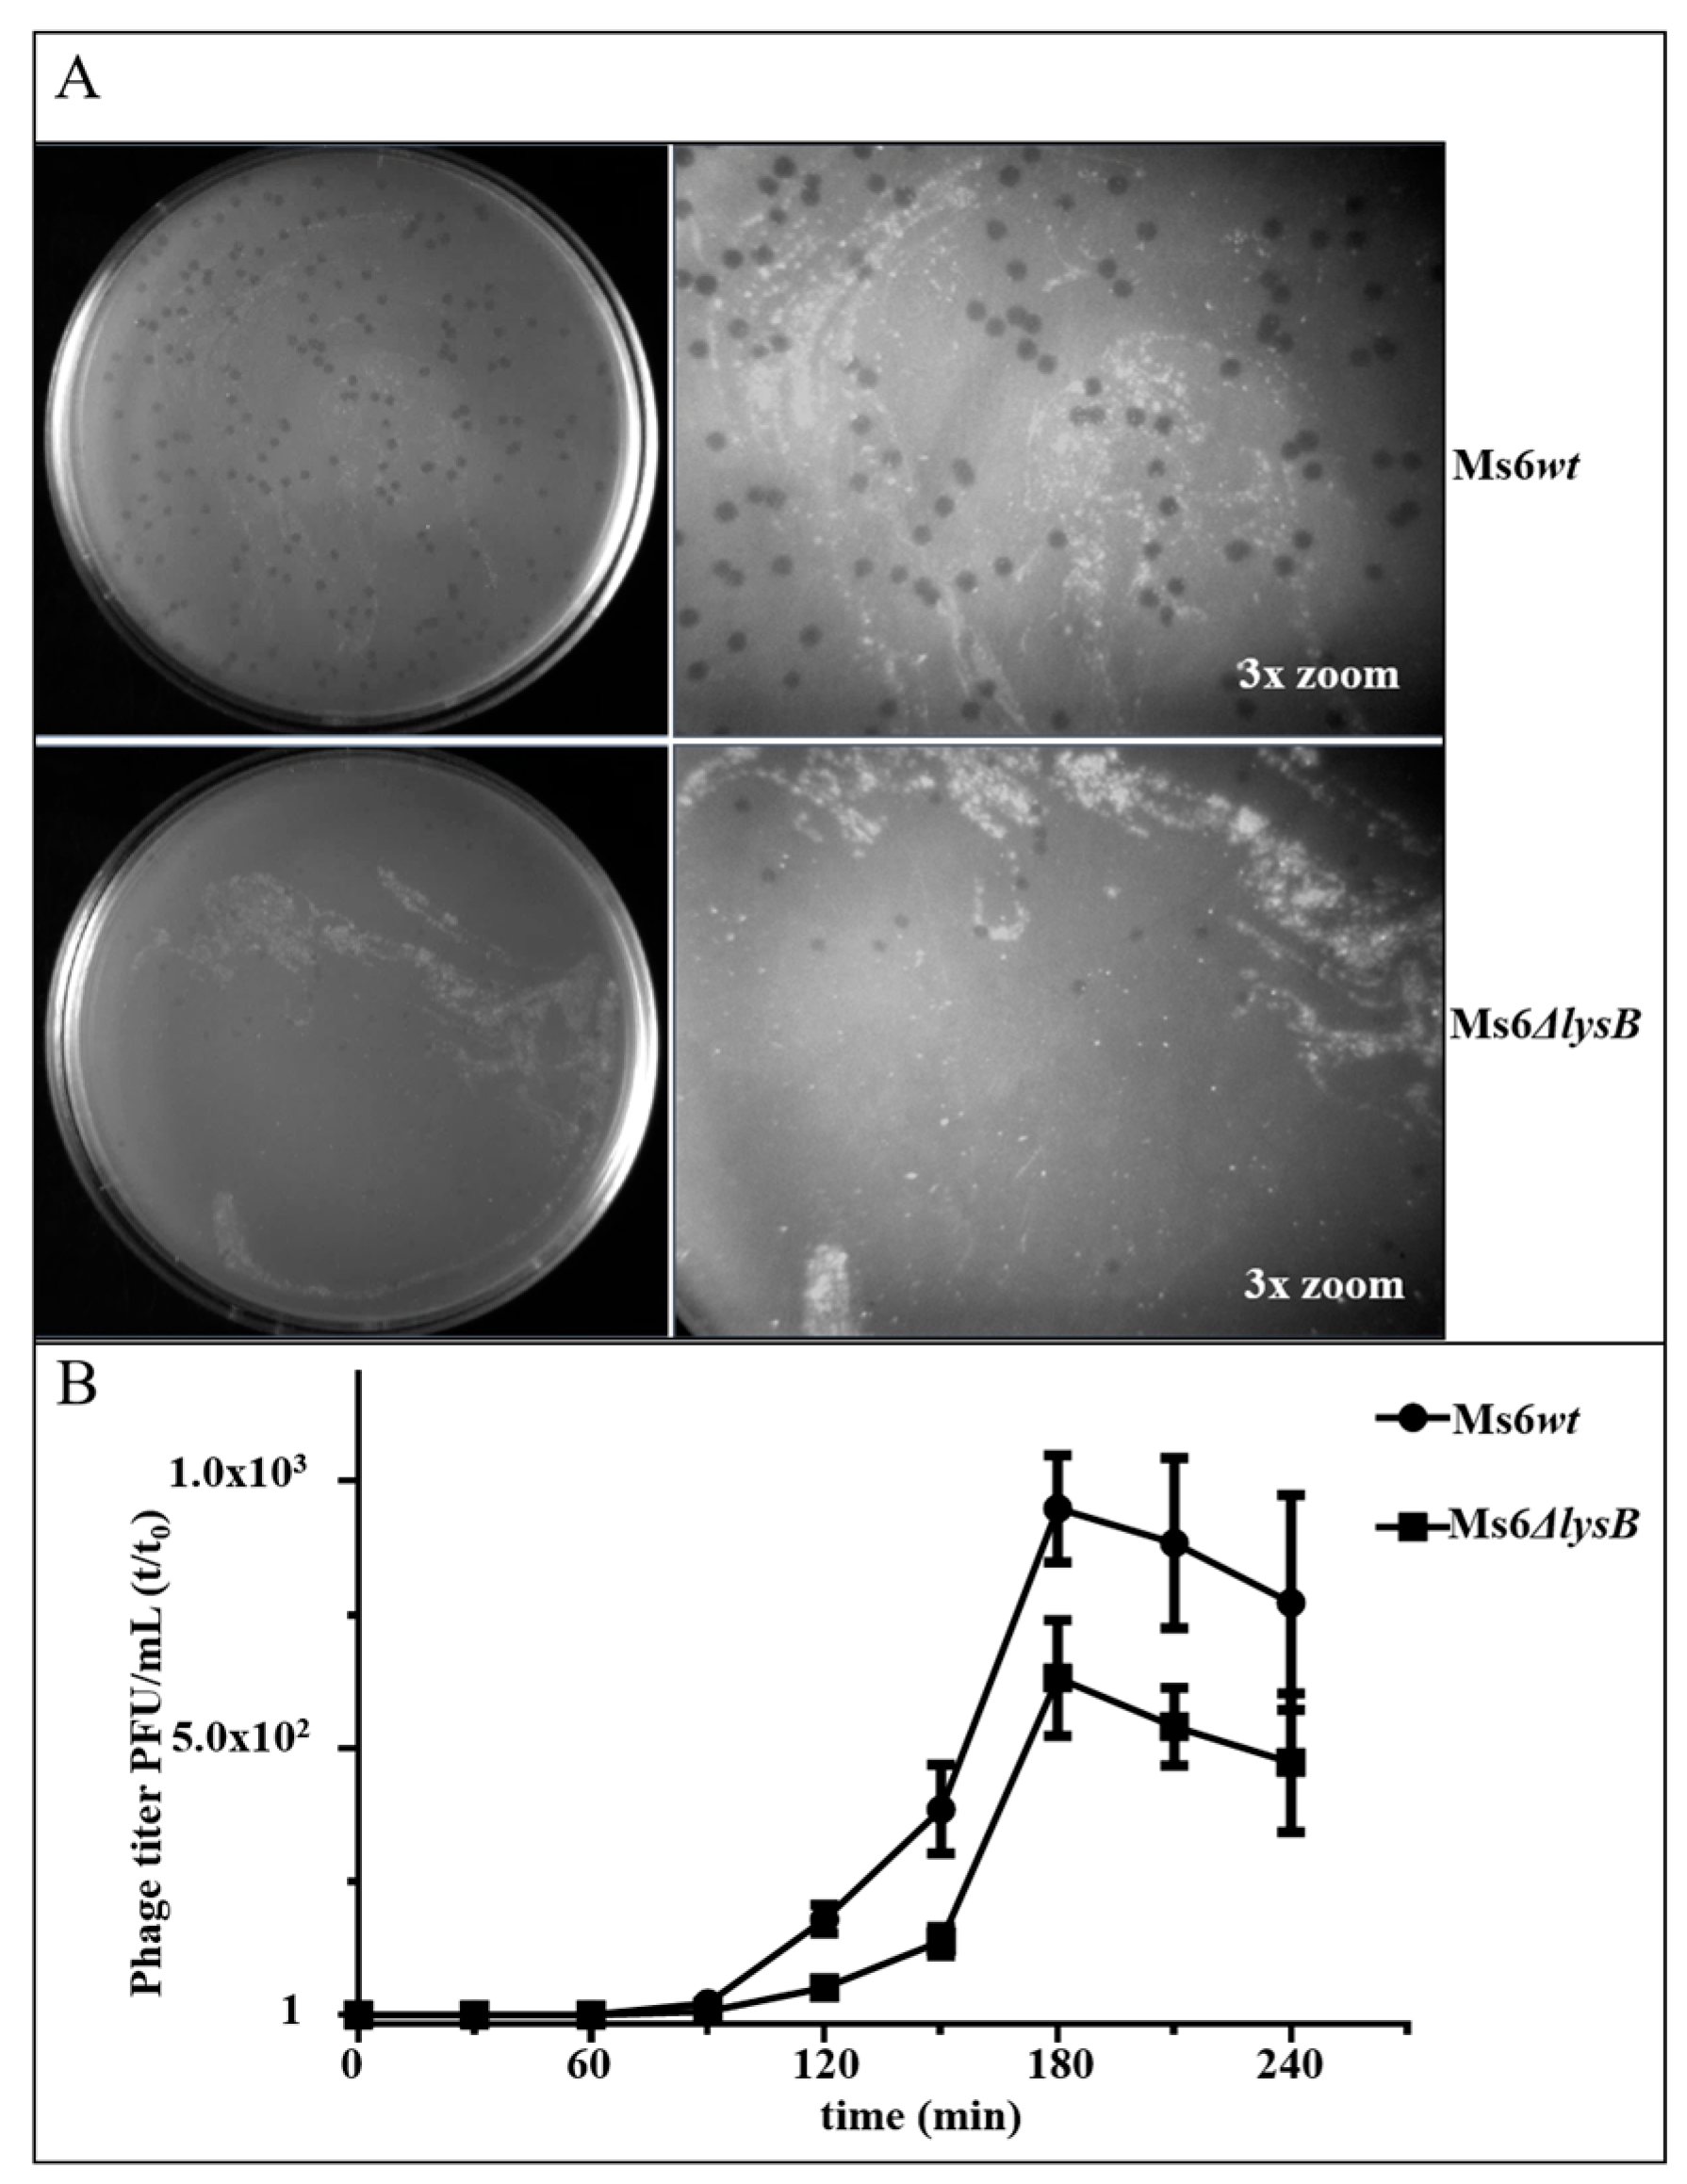
Viruses 09 00343 g002 Viruses 09 00343 g002

The Ms6 Mycolyl-Arabinogalactan Esterase LysB is Essential for an Efficient Mycobacteriophage-Induced Lysis
Abstract
1. Introduction
2. Materials and Methods
2.1. Bacterial Strains, Phages, Plasmids and Culture Conditions
2.2. Construction of Ms6 Mutant Phage
2.3. Plasmid Construction
2.4. One Step Growth and Single Burst Experiments
2.5. Determination of the Number of Phage Particles Released during the Infection Cycle
2.6. Cryo-Transmission Electron Microscopy Sample Preparation, Imaging and Image Processing
2.7. Nucleotide Sequence Accession Numbers
3. Results
3.1. Ms6 LysB Deletion Decreases Viral Progeny Release
3.2. Ms6 Is Trapped in Cell Debris in Absence of LysB
3.3. Cryo-EM Shows Incomplete Cell Lysis in Absence of Ms6 LysB
4. Discussion
Supplementary Material
Acknowledgments
Author Contributions
Conflicts of Interest
References
- Rodriguez-Valera, F.; Martin-Cuadrado, A.-B.; Rodriguez-Brito, B.; Pasić, L.; Thingstad, T.F.; Rohwer, F.; Mira, A. Explaining microbial population genomics through phage predation. Nat. Rev. Microbiol. 2009, 7, 828–836. [Google Scholar] [CrossRef] [PubMed]
- Hatfull, G.F.; Hendrix, R.W. Bacteriophages and their genomes. Curr. Opin. Virol. 2011, 1, 298–303. [Google Scholar] [CrossRef] [PubMed]
- Ackermann, H.W.; Prangishvili, D. Prokaryote viruses studied by electron microscopy. Arch. Virol. 2012, 157, 1843–1849. [Google Scholar] [CrossRef] [PubMed]
- Young, R.; Wang, I.N. Phage lysis. In The Bacteriophages; Calendar, R., Ed.; Oxford University Press: New York, NY, USA, 2006; pp. 104–125. [Google Scholar]
- Catalão, M.J.; Gil, F.; Moniz-Pereira, J.; São-José, C.; Pimentel, M. Diversity in bacterial lysis systems: Bacteriophages show the way. FEMS Microbiol. Rev. 2013, 37, 554–571. [Google Scholar] [CrossRef] [PubMed]
- Rajaure, M.; Berry, J.; Kongari, R.; Cahill, J.; Young, R. Membrane fusion during phage lysis. Proc. Natl. Acad. Sci. USA 2015, 112, 5497–5502. [Google Scholar] [CrossRef] [PubMed]
- Berry, J.; Summer, E.J.; Struck, D.K.; Young, R. The final step in the phage infection cycle: The Rz and Rz1 lysis proteins link the inner and outer membranes. Mol. Microbiol. 2008, 70, 341–351. [Google Scholar] [CrossRef] [PubMed]
- Berry, J.; Savva, C.; Holzenburg, A.; Young, R. The lambda spanin components Rz and Rz1 undergo tertiary and quaternary rearrangements upon complex formation. Protein Sci. 2010, 19, 1967–1977. [Google Scholar] [CrossRef] [PubMed]
- Berry, J.; Rajaure, M.; Pang, T.; Young, R. The spanin complex is essential for lambda lysis. J. Bacteriol. 2012, 194, 5667–5674. [Google Scholar] [CrossRef] [PubMed]
- Summer, E.J.; Berry, J.; Tran, T.A.T.; Niu, L.; Struck, D.K.; Young, R. Rz/Rz1 Lysis Gene Equivalents in Phages of Gram-negative Hosts. J. Mol. Biol. 2007, 373, 1098–1112. [Google Scholar] [CrossRef] [PubMed]
- Krupovič, M.; Cvirkaitė-Krupovič, V.; Bamford, D.H. Identification and functional analysis of the Rz/Rz1-like accessory lysis genes in the membrane-containing bacteriophage PRD1. Mol. Microbiol. 2008, 68, 492–503. [Google Scholar] [CrossRef] [PubMed]
- Pimentel, M. Genetics of Phage Lysis. Microbiol. Spectr. 2014, 2, 1–13. [Google Scholar] [CrossRef] [PubMed]
- Mamadou, D.; Marie-Ange, D.; Nicole, G. The cell envelope of Mycobacterium smegmatis: Cytochemistry and architectural implications. FEMS Microbiol. Lett. 1989, 52, 89–93. [Google Scholar] [CrossRef] [PubMed]
- Daffé, M. The Global Architecture of the Mycobacterial Cell Envelope. In The Mycobacterial Cell Envelope; Daffé, M., Reyrat, J., Avenir, G., Eds.; ASM Press: Washington, DC, USA, 2008; pp. 3–11. ISBN 9781555814687. [Google Scholar]
- Brennan, P. Structure, function, and biogenesis of the cell wall of Mycobacterium tuberculosis. Tuberculosis 2003, 83, 91–97. [Google Scholar] [CrossRef]
- Hoffmann, C.; Leis, A.; Niederweis, M.; Plitzko, J.M.; Engelhardt, H. Disclosure of the mycobacterial outer membrane: Cryo-electron tomography and vitreous sections reveal the lipid bilayer structure. Proc. Natl. Acad. Sci. USA 2008, 105, 3963–3967. [Google Scholar] [CrossRef] [PubMed]
- Zuber, B.; Chami, M.; Houssin, C.; Dubochet, J.; Griffiths, G.; Daffe, M. Direct Visualization of the Outer Membrane of Native Mycobacteria and Corynebacteria. J. Bacteriol. 2008, 190, 5672–5680. [Google Scholar] [CrossRef] [PubMed]
- Lemassu, A.; Ortalo-Magné, A.; Bardou, F.; Silve, G.; Laneélle, M.A.; Daffé, M. Extracellular and surface-exposed polysaccharides of non-tuberculous mycobacteria. Microbiology 1996, 142, 1513–1520. [Google Scholar] [CrossRef] [PubMed]
- Sani, M.; Houben, E.N.G.; Geurtsen, J.; Pierson, J.; de Punder, K.; van Zon, M.; Wever, B.; Piersma, S.R.; Jiménez, C.R.; Daffé, M.; et al. Direct visualization by Cryo-EM of the mycobacterial capsular layer: A labile structure containing ESX-1-secreted proteins. PLoS Pathog. 2010, 6, e1000794. [Google Scholar] [CrossRef] [PubMed]
- Garcia, M.; Pimentel, M.; Moniz-Pereira, J. Expression of mycobacteriophage Ms6 lysis genes is driven by two σ70-like promoters and is dependent on a transcription termination signal present in the leader RNA. J. Bacteriol. 2002, 184, 3034–3043. [Google Scholar] [CrossRef] [PubMed]
- Catalão, M.J.; Gil, F.; Moniz-Pereira, J.; Pimentel, M. The mycobacteriophage Ms6 encodes a chaperone-like protein involved in the endolysin delivery to the peptidoglycan. Mol. Microbiol. 2010, 77, 672–686. [Google Scholar] [CrossRef] [PubMed]
- Catalão, M.J.; Gil, F.; Moniz-Pereira, J.; Pimentel, M. The endolysin-binding domain encompasses the N-terminal region of the mycobacteriophage Ms6 Gp1 chaperone. J. Bacteriol. 2011, 193, 5002–5006. [Google Scholar] [CrossRef] [PubMed]
- Catalão, M.J.; Milho, C.; Gil, F.; Moniz-Pereira, J.; Pimentel, M. A second endolysin gene is fully embedded in-frame with the lysA gene of mycobacteriophage Ms6. PLoS ONE 2011, 6, e20515. [Google Scholar] [CrossRef] [PubMed]
- Gil, F.; Catalão, M.J.; Moniz-Pereira, J.; Leandro, P.; McNeil, M.; Pimentel, M. The lytic cassette of mycobacteriophage Ms6 encodes an enzyme with lipolytic activity. Microbiology 2008, 154, 1364–1371. [Google Scholar] [CrossRef] [PubMed]
- Gil, F.; Grzegorzewicz, A.E.; Catalão, M.J.; Vital, J.; McNeil, M.R.; Pimentel, M. Mycobacteriophage Ms6 LysB specifically targets the outer membrane of Mycobacterium smegmatis. Microbiology 2010, 156, 1497–1504. [Google Scholar] [CrossRef] [PubMed]
- Snapper, S.B.; Melton, R.E.; Mustafa, S.; Kieser, T.; Jacobs, W.R., Jr. Isolation and characterization of efficient plasmid transformation mutants of Mycobacterium smegmatis. Mol. Microbiol. 1990, 4, 1911–1919. [Google Scholar] [CrossRef] [PubMed]
- Portugal, I.; Anes, E.; Moniz-Pereira, J. Temperate mycobacteriophage from M. smegmatis. Acta Leprol. 1989, 1, 243–244. [Google Scholar]
- Van Kessel, J.C.; Hatfull, G.F. Recombineering in Mycobacterium tuberculosis. Nat. Methods 2007, 4, 147–152. [Google Scholar] [CrossRef] [PubMed]
- Vissa, V.; McNeil, M.; Department of Microbiology, Immunology and Pathology, Colorado State University, Fort Collins; CO 80523, USA. pVVAp is a mycobacteria shuttle vector, containing the pAL5000 replication origin, the kanamycin resistance gene and the acetamidase promoter region. 2008. [Google Scholar]
- Marinelli, L.J.; Piuri, M.; Swigoňová, Z.; Balachandran, A.; Oldfield, L.M.; van Kessel, J.C.; Hatfull, G.F. BRED: A simple and powerful tool for constructing mutant and recombinant bacteriophage genomes. PLoS ONE 2008, 3, e3957. [Google Scholar] [CrossRef] [PubMed]
- Sambrook, J.; Russell, D.W. Molecular cloning: A laboratory manual, 3rd ed.; Cold Spring Harbor Laboratory Press: Cold Spring Harbor, NY, USA, 2001; ISBN 0879695773. [Google Scholar]
- Adams, M.H. Methods of study of bacterial viruses. In Bacteriophages; Adams, M.H., Ed.; Interscience Publishers, Inc.: New York, NY, USA, 1959; pp. 443–522. [Google Scholar]
- Kremer, J.R.; Mastronarde, D.N.; McIntosh, J.R. Computer visualization of three-dimensional image data using IMOD. J. Struct. Biol. 1996, 116, 71–76. [Google Scholar] [CrossRef] [PubMed]
- Mastronarde, D.N. Dual-axis tomography: An approach with alignment methods that preserve resolution. J. Struct. Biol. 1997, 120, 343–352. [Google Scholar] [CrossRef] [PubMed]
- Mastronarde, D.N. Automated electron microscope tomography using robust prediction of specimen movements. J. Struct. Biol. 2005, 152, 36–51. [Google Scholar] [CrossRef] [PubMed]
- Zhang, N.; Young, R. Complementation and characterization of the nested Rz and Rz1 reading frames in the genome of bacteriophage λ. Mol. Gen. Genet. MGG 1999, 262, 659–667. [Google Scholar] [CrossRef] [PubMed]
- Markov, D.; Christie, G.E.; Sauer, B.; Calendar, R.; Park, T.; Young, R.; Severinov, K. P2 growth restriction on an rpoC mutant is suppressed by alleles of the Rz1 homolog lysC. J. Bacteriol. 2004, 186, 4628–4637. [Google Scholar] [CrossRef] [PubMed]
- Payne, K.; Sun, Q.; Sacchettini, J.; Hatfull, G.F. Mycobacteriophage lysin B is a novel mycolylarabinogalactan esterase. Mol. Microbiol. 2009, 73, 367–381. [Google Scholar] [CrossRef] [PubMed]
- Berry, J.D.; Rajaure, M.; Young, R. Spanin function requires subunit homodimerization through intermolecular disulfide bonds. Mol. Microbiol. 2013, 88, 35–47. [Google Scholar] [CrossRef] [PubMed]
- Jackson, M. The mycobacterial cell envelope-lipids. Cold Spring Harb. Perspect. Med. 2014, 4, a021105. [Google Scholar] [CrossRef] [PubMed]
- Summer, E.J.; Liu, M.; Gill, J.J.; Grant, M.; Chan-Cortes, T.N.; Ferguson, L.; Janes, C.; Lange, K.; Bertoli, M.; Moore, C.; et al. Genomic and functional analyses of Rhodococcus equi phages ReqiPepy6, ReqiPoco6, ReqiPine5, and ReqiDocB7. Appl. Environ. Microbiol. 2011, 77, 669–683. [Google Scholar] [CrossRef] [PubMed]
- Pope, W.H.; Mavrich, T.N.; Garlena, R.A.; Guerrero-Bustamante, C.A.; Jacobs-Sera, D.; Montgomery, M.T.; Russell, D.A.; Warner, M.H.; Science Education Alliance-Phage Hunters Advancing Genomics and Evolutionary Science (SEA-PHAGES); Hatfull, G.F. Bacteriophages of Gordonia spp. display a spectrum of diversity and genetic relationships. MBio 2017, 8, e01069-17. [Google Scholar] [CrossRef] [PubMed]

| Name | Description | Source or Reference |
|---|---|---|
| Bacteria | ||
| Mycobacterium smegmatis mc2155 | High-transformation-efficiency mutant of M. smegmatis ATCC 607 | [26] |
| Bacteriophages | ||
| Ms6wt | Temperate bacteriophage from M. smegmatis | [27] |
| Ms6ΔlysB | 996 bp in-frame deletion of the Ms6 lysB gene | This study |
| Plasmids | ||
| pJV53 pAG1 | Derivative of pLAM12 with Che9c 60 and 61 under control of the acetamidase promoter; Kanr lysB gene cloned into pVVAP | [28] This study |
| pVVAP | Mycobacteria shuttle vector carrying the acetamidase promoter; Kanr | [29] |
| Oligonucleotides | Sequence 5’-3’ a | |
| PrΔlysB | CTCGGCGGAAAAACCCTCCTCGTGGACGCGGTAGCAGAACTGTTGGGCCACTGATAGGAGGCACCCATGCTGACACGTTCATTCTGGATCGACGCCGCCGAGCG | Ms6ΔlysB |
| PrExtΔlysBFw | CGAGATCCTGCGGCAACTGCGCGGATACAACCTCACTGGCTGGCCGCAGCTCGGCGGAAAAACCCTCGTGGACG | Extend Pr∆lysB |
| PrExtΔlysBRv | CCCCGGCGCCGAGGGTGGCGATCGCGGTTTGGGCGAATGTGCGTATGGCACGCTCGGCGGCGTCGATCCAGAATG | Extend Pr∆lysB |
| PrlysBFw | GCGGATCCATGAGCAGAACTGTTGGGCC | Includes BamHI site to clone in pVVAP |
| PrlysBRv | GGAAGCTTTGTGCGTAGGTAGTCGATG | Includes HindIII site to clone in pVVAP |
| DADA ΔlysB PCRFw | GCGCTAGCAGAACTGTTGGGCCACTGATAG | Ms6ΔlysB |
| DADA Ms6-PCRRv | CGTCTCGTACTGCACGTACCGGTTCTTC | Ms6ΔlysB |
© 2017 by the authors. Licensee MDPI, Basel, Switzerland. This article is an open access article distributed under the terms and conditions of the Creative Commons Attribution (CC BY) license (http://creativecommons.org/licenses/by/4.0/).
Share and Cite
Gigante, A.M.; Hampton, C.M.; Dillard, R.S.; Gil, F.; Catalão, M.J.; Moniz-Pereira, J.; Wright, E.R.; Pimentel, M. The Ms6 Mycolyl-Arabinogalactan Esterase LysB is Essential for an Efficient Mycobacteriophage-Induced Lysis. Viruses 2017, 9, 343. https://doi.org/10.3390/v9110343
Gigante AM, Hampton CM, Dillard RS, Gil F, Catalão MJ, Moniz-Pereira J, Wright ER, Pimentel M. The Ms6 Mycolyl-Arabinogalactan Esterase LysB is Essential for an Efficient Mycobacteriophage-Induced Lysis. Viruses. 2017; 9(11):343. https://doi.org/10.3390/v9110343
Chicago/Turabian StyleGigante, Adriano M., Cheri M. Hampton, Rebecca S. Dillard, Filipa Gil, Maria João Catalão, José Moniz-Pereira, Elizabeth R. Wright, and Madalena Pimentel. 2017. "The Ms6 Mycolyl-Arabinogalactan Esterase LysB is Essential for an Efficient Mycobacteriophage-Induced Lysis" Viruses 9, no. 11: 343. https://doi.org/10.3390/v9110343
APA StyleGigante, A. M., Hampton, C. M., Dillard, R. S., Gil, F., Catalão, M. J., Moniz-Pereira, J., Wright, E. R., & Pimentel, M. (2017). The Ms6 Mycolyl-Arabinogalactan Esterase LysB is Essential for an Efficient Mycobacteriophage-Induced Lysis. Viruses, 9(11), 343. https://doi.org/10.3390/v9110343

